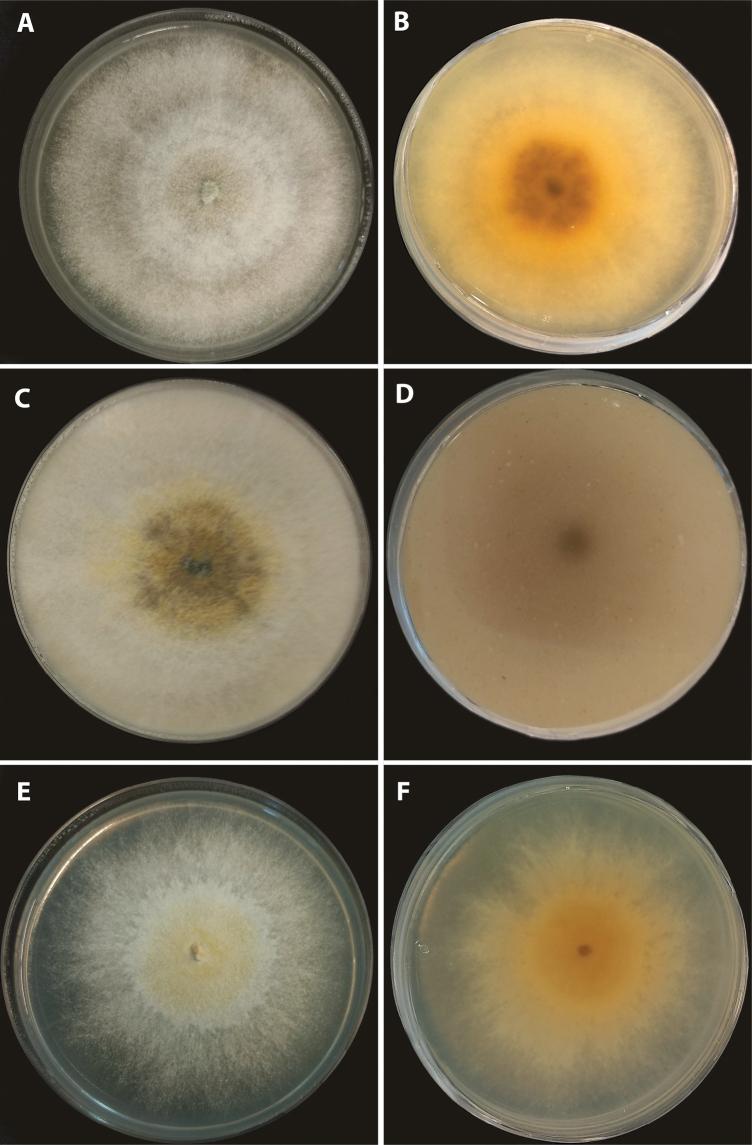

通过多相分类学方法将 属(炭角菌科,炭角菌目)从 中分离出来。
Segregation of the genus (Hypoxylaceae, Xylariales) from by a polyphasic taxonomic approach.
作者信息
Cedeño-Sanchez Marjorie, Charria-Girón Esteban, Lambert Christopher, Luangsa-Ard J Jennifer, Decock Cony, Franke Raimo, Brönstrup Mark, Stadler Marc
机构信息
Dept. Microbial Drugs, Helmholtz Centre for Infectiion Research, Inhoffenstrasse 7, 38124 Braunschweig, Germany.
Institute of Microbiology, Technische Universität Braunschweig, Spielmannstraße 7, 38106 Braunschweig, Germany.
出版信息
MycoKeys. 2023 Feb 20;95:131-162. doi: 10.3897/mycokeys.95.98125. eCollection 2023.
During a mycological survey of the Democratic Republic of the Congo, a fungal specimen that morphologically resembled the American species was encountered. A polyphasic approach including morphological and chemotaxonomic together with a multigene phylogenetic study (ITS, LSU, , and ) of spp. and representatives of related genera revealed that this strain represents a new species of the Hypoxylaceae. However, the multi-locus phylogenetic inference indicated that the new fungus clustered with in a separate clade from the other species of . Studies by ultrahigh performance liquid chromatography coupled to diode array detection and ion mobility tandem mass spectrometry (UHPLC-DAD-IM-MS/MS) were carried out on the stromatal extracts. In particular, the MS/MS spectra of the major stromatal metabolites of these species indicated the production of hitherto unreported azaphilone pigments with a similar core scaffold to the cohaerin-type metabolites, which are exclusively found in the Hypoxylaceae. Based on these results, the new genus is introduced herein. Aside from , the genus also includes , which clustered together with the type species within a basal clade of the Hypoxylaceae together with its sister genus .
在对刚果民主共和国进行的真菌学调查中,发现了一个形态上与美国物种相似的真菌标本。一种多相方法,包括形态学和化学分类学,以及对 spp. 和相关属代表的多基因系统发育研究(ITS、LSU、 和 ),表明该菌株代表了炭角菌科的一个新物种。然而,多位点系统发育推断表明,这种新真菌与 在一个独立的分支中聚类,与 的其他物种分开。对基质提取物进行了超高效液相色谱结合二极管阵列检测和离子淌度串联质谱(UHPLC-DAD-IM-MS/MS)研究。特别是,这些物种主要基质代谢物的 MS/MS 光谱表明,产生了迄今未报道的氮杂萘酮色素,其核心支架与仅在炭角菌科中发现的 cohaerin 型代谢物相似。基于这些结果,本文引入了新属 。除了 之外,该属还包括 ,它与模式物种一起聚集在炭角菌科的一个基部类群中,与其姐妹属 在一起。